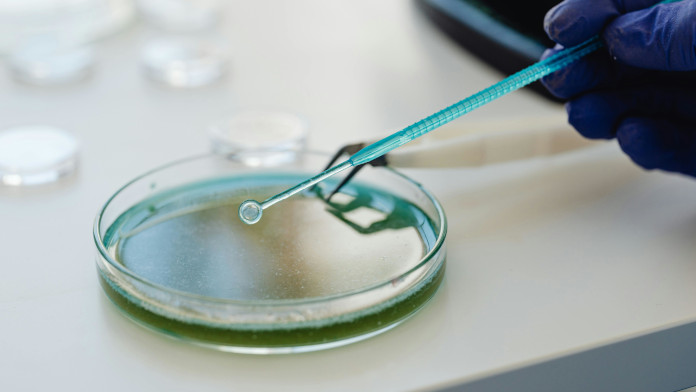

- La nueva ley también establece la obligación de recabar el consentimiento expreso de las personas objeto de una prueba genética
El Consejo de Ministros ha aprobado este martes un nuevo Real Decreto (RD) de productos sanitarios para diagnóstico ‘in vitro’, cuyo objetivo es garantizar un «alto nivel de protección» de la salud y la seguridad de los pacientes y usuarios, fomentando la transparencia, la sostenibilidad y la innovación.
Este texto concreta y desarrolla a nivel nacional los aspectos que el Reglamento (UE) 2017/746 deja a la regulación de los Estados miembros, estableciendo que la fabricación de los productos en centros sanitarios para uso exclusivo interno deberá cumplir con requisitos específicos de seguridad y calidad, así como ser comunicada a la Agencia Española de Medicamentos y Productos Sanitarios (AEMPS).
Cabe destacar que la propia AEMPS será la autoridad competente para la aplicación del reglamento europeo, en coordinación con las comunidades autónomas, quienes organizarán un sistema reforzado de vigilancia, inspección y control del mercado.
La nueva ley también establece la obligación de recabar el consentimiento expreso de las personas objeto de una prueba genética y de proporcionarles información adecuada sobre la naturaleza, la importancia y las consecuencias de la misma.
En el documento se recoge igualmente que aquellos productos de autodiagnóstico, como las pruebas de embarazo o de glucosa, no requieren de prescripción médica, si bien su dispensación seguirá limitada a oficinas de farmacia y a sus canales digitales autorizados.
Asimismo, se define el procedimiento para la designación y funcionamiento de los laboratorios de referencia europeos con sede en España, y se dispone la creación de un registro nacional de comercialización, que será obligatorio para los agentes económicos que introduzcan productos en el mercado español una vez esté plenamente operativo.
El Gobierno ha incluido una serie de disposiciones sobre comercio exterior, regulando la importación y exportación de estos productos para «asegurar» su trazabilidad y el cumplimiento de la actual normativa.
Esta legislación deroga igualmente el Real Decreto 1662/2000, de 29 de septiembre, manteniéndose en vigor de forma transitoria aquellos artículos que todavía resulten necesarios hasta la plena implementación del nuevo marco normativo. El Ministerio de Sanidad podrá dictar las disposiciones complementarias que resulten necesarias para su aplicación o adaptación técnica.
Para facilitar la transición al nuevo marco regulador, la AEMPS celebrará el próximo 4 de diciembre una jornada informativa en línea dirigida a profesionales y agentes del sector.

